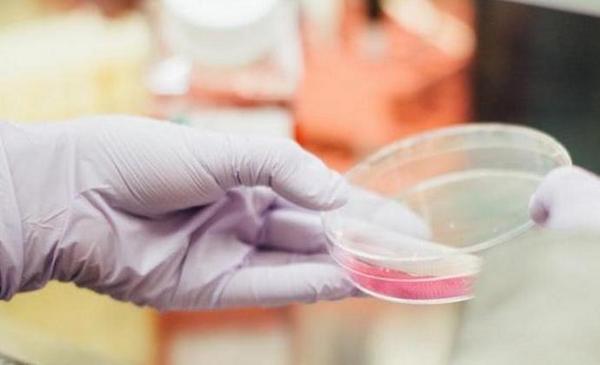

От Клуни до Хаапасало: мужчины, которые не побоялись стать женщинами
https://vse42.ru/articles/31173985
В древнегреческом театре все женские роли исполняли мужчины. Сегодня к этому относятся иначе. Мужик в юбке – скандал, эпатаж, провокация! И все же мы решили вспомнить актеров, которые не побоялись переодеться в дам и предстать перед публикой.
https://vse42.ru/articles/31173985
В древнегреческом театре все женские роли исполняли мужчины. Сегодня к этому относятся иначе. Мужик в юбке – скандал, эпатаж, провокация! И все же мы решили вспомнить актеров, которые не побоялись переодеться в дам и предстать перед публикой.
Задолженность потребителей перед СГК выросла в апреле на 40 процентов
https://vse42.ru/news/31174001
Платежи за отопление и электроэнергию, которые поставляют субъектам малого бизнеса предприятия Сибирской генерирующей компании (СГК), упали на 40 процентов. Об этом сообщила директор по тарифообразовнию СГК Екатерина Косогова.
https://vse42.ru/news/31174001
Платежи за отопление и электроэнергию, которые поставляют субъектам малого бизнеса предприятия Сибирской генерирующей компании (СГК), упали на 40 процентов. Об этом сообщила директор по тарифообразовнию СГК Екатерина Косогова.
Работа в Кемерово и Кузбассе

Работа в Кемерово: Актуальные вакансии и резюме. Удобный поиск работы в Кемерово. На нашем сайте Вы сможете найти работу в кратчайшие сроки.Работа в Кемерово: Актуальные вакансии и резюме. Удобный поиск работы в Кемерово. На нашем сайте Вы сможете найти работу в кратчайшие сроки.
Ссылка https://rabota.vse42.ru/vacancy/31173933
"Моя Муза": Киркоров "нежно" обратился к Пугачевой
https://vse42.ru/news/31174048
Примадонна отечественной эстрады Алла Пугачева 15 апреля празднует день рождения. В честь 71-летия артистки Филипп Киркоров "трогательно" поздравил ее.
https://vse42.ru/news/31174048
Примадонна отечественной эстрады Алла Пугачева 15 апреля празднует день рождения. В честь 71-летия артистки Филипп Киркоров "трогательно" поздравил ее.
Комаровский связал высокую смертность в Италии от коронавируса с антибиотиками
https://vse42.ru/news/31174042
Доктор и ведущий выпусков о здоровье Евгений Комаровский рассказал, что случаи летальных исходов в Италии высокий из-за массового приема антибиотиков. Данное предположение он объяснил на своем YouTube-канале.
https://vse42.ru/news/31174042
Доктор и ведущий выпусков о здоровье Евгений Комаровский рассказал, что случаи летальных исходов в Италии высокий из-за массового приема антибиотиков. Данное предположение он объяснил на своем YouTube-канале.
Число самоизолированных из-за коронавируса кузбассовцев уменьшилось в три раза за сутки
По последним данным, за прошедший день на улицу смогли впервые выйти после двухнедельного карантина тысячи кузбассовцев.
https://vse42.ru/news/31174020
По последним данным, за прошедший день на улицу смогли впервые выйти после двухнедельного карантина тысячи кузбассовцев.
https://vse42.ru/news/31174020
Еще один кузбассовец вылечился от коронавируса
https://avoka.do/posts/esche-odin-kuzbassovets-vylechilsya-ot-koronavirusa
Он стал уже четвертым жителем области, справившимся с СOVID-19.
https://avoka.do/posts/esche-odin-kuzbassovets-vylechilsya-ot-koronavirusa
Он стал уже четвертым жителем области, справившимся с СOVID-19.

Он стал уже четвертым жителем области, справившимся с СOVID-19.
Ссылка https://avoka.do/posts/esche-odin-kuzbassovets-vylechilsya-ot-koronavirusa
Работа в Кемерово и Кузбассе

Работа в Кемерово: Актуальные вакансии и резюме. Удобный поиск работы в Кемерово. На нашем сайте Вы сможете найти работу в кратчайшие сроки.Работа в Кемерово: Актуальные вакансии и резюме. Удобный поиск работы в Кемерово. На нашем сайте Вы сможете найти работу в кратчайшие сроки.
Ссылка https://rabota.vse42.ru/vacancy/30903165
Четвертый кузбассовец излечился от коронавирусной инфекции
В Кемеровской области зафиксирован новый случай выздоровления от COVID-19. Он стал четвертым человеком, переболевшим коронавирусом в Кузбассе.
https://vse42.ru/news/31174021
В Кемеровской области зафиксирован новый случай выздоровления от COVID-19. Он стал четвертым человеком, переболевшим коронавирусом в Кузбассе.
https://vse42.ru/news/31174021
"Местный иммунитет": Комаровский рассказал о категории "стойких" к коронавирусу людей
https://vse42.ru/news/31173997
Известный врач и телеведущий Евгений Комаровский в своем шоу на YouTube-канале поделился, что есть люди, которые не "подхватывают" COVID-19 из-за хорошего местного иммунитета, даже находясь в тесном контакте с инфицированным.
https://vse42.ru/news/31173997
Известный врач и телеведущий Евгений Комаровский в своем шоу на YouTube-канале поделился, что есть люди, которые не "подхватывают" COVID-19 из-за хорошего местного иммунитета, даже находясь в тесном контакте с инфицированным.

Особый противопожарный режим введен в Кузбассе
https://avoka.do/posts/osobyy-protivopozharnyy-rezhim-vveden-v-kuzbasse
Он действует в регионе с сегодняшнего дня и до начала лета. На это время в два раза возрастут штрафные санкции для нарушителей.
https://avoka.do/posts/osobyy-protivopozharnyy-rezhim-vveden-v-kuzbasse
Он действует в регионе с сегодняшнего дня и до начала лета. На это время в два раза возрастут штрафные санкции для нарушителей.

Он действует в регионе с сегодняшнего дня и до начала лета. На это время в два раза возрастут штрафные санкции для нарушителей.
Ссылка https://avoka.do/posts/osobyy-protivopozharnyy-rezhim-vveden-v-kuzbasse
---------------— #выставка_vse42 —------------—
Зал Диониса. Римская декоративная скульптура (6+)
https://afisha.vse42.ru/c-event/view/id/16120#content-start
Зал Диониса. Римская декоративная скульптура (6+)
https://afisha.vse42.ru/c-event/view/id/16120#content-start
"В шею вставлена трубка": появились подробности состояния Бабкиной
https://vse42.ru/news/31174015
Появилась информация, что состояние Надежды Бабкиной по-прежнему тяжелое. Артистка до сих пор подключена к аппарату искусственной вентиляции легких.
https://vse42.ru/news/31174015
Появилась информация, что состояние Надежды Бабкиной по-прежнему тяжелое. Артистка до сих пор подключена к аппарату искусственной вентиляции легких.
Навка показала на видео подарки со своего дня рождения (фото)
https://vse42.ru/news/31173989
Супруга пресс-секретаря президента России Дмитрия Пескова Татьяна Навка продемонстрировала пользователям Сети подарки, преподнесенные ей в честь юбилея.
https://vse42.ru/news/31173989
Супруга пресс-секретаря президента России Дмитрия Пескова Татьяна Навка продемонстрировала пользователям Сети подарки, преподнесенные ей в честь юбилея.

Еще один кузбассовец вылечился от коронавируса
https://avoka.do/posts/esche-odin-kuzbassovets-vylechilsya-ot-koronavirusa
Он стал уже четвертым жителем области, справившимся с СOVID-19.
https://avoka.do/posts/esche-odin-kuzbassovets-vylechilsya-ot-koronavirusa
Он стал уже четвертым жителем области, справившимся с СOVID-19.
Он стал уже четвертым жителем области, справившимся с СOVID-19.
Ссылка https://avoka.do/posts/esche-odin-kuzbassovets-vylechilsya-ot-koronavirusa
7 000 кузбассовцев подхватили вирус за неделю
За минувшую неделю с симптомами вирусной инфекции обратились к врачу тысячи человек, у части был взят клинический материал для анализа.
https://vse42.ru/news/31173995
За минувшую неделю с симптомами вирусной инфекции обратились к врачу тысячи человек, у части был взят клинический материал для анализа.
https://vse42.ru/news/31173995
За прошедшие сутки в Кузбассе выявлено 4 человека с коронавирусом
Число граждан, у которых диагностирован COVID-19 в Кемеровской области, достигло 19. Об этом сообщили в оперативном штабе Кузбасса по региону.
https://vse42.ru/news/31174018
Число граждан, у которых диагностирован COVID-19 в Кемеровской области, достигло 19. Об этом сообщили в оперативном штабе Кузбасса по региону.
https://vse42.ru/news/31174018
Особый противопожарный режим введен в Кузбассе
https://avoka.do/posts/osobyy-protivopozharnyy-rezhim-vveden-v-kuzbasse
Он действует в регионе с сегодняшнего дня и до начала лета. На это время в два раза возрастут штрафные санкции для нарушителей.
https://avoka.do/posts/osobyy-protivopozharnyy-rezhim-vveden-v-kuzbasse
Он действует в регионе с сегодняшнего дня и до начала лета. На это время в два раза возрастут штрафные санкции для нарушителей.

Он действует в регионе с сегодняшнего дня и до начала лета. На это время в два раза возрастут штрафные санкции для нарушителей.
Ссылка https://avoka.do/posts/osobyy-protivopozharnyy-rezhim-vveden-v-kuzbasse
Россияне выразили готовность начать больше работать после окончания самоизоляции
https://vse42.ru/news/31173998
Специалисты сервиса по интернет-рекрутменту провели исследование и выяснили, что после окончания режима самоизоляции большинство россиян готовы начать трудиться больше обычного.
https://vse42.ru/news/31173998
Специалисты сервиса по интернет-рекрутменту провели исследование и выяснили, что после окончания режима самоизоляции большинство россиян готовы начать трудиться больше обычного.
Власти Кузбасса решили нарастить экспорт угля за счет отмены пассажирских перевозок
Губернатор Кемеровской области Сергей Цивилев направил в адрес руководства РЖД письмо с просьбой рассмотреть возможность увеличения перевозок угля сверх плана в связи с отменой пассажирского сообщения на железной дороге.
https://vse42.ru/news/31173991
Губернатор Кемеровской области Сергей Цивилев направил в адрес руководства РЖД письмо с просьбой рассмотреть возможность увеличения перевозок угля сверх плана в связи с отменой пассажирского сообщения на железной дороге.
https://vse42.ru/news/31173991
Почти семь тысяч кузбассовцев заболели гриппом и ОРВИ за неделю
https://avoka.do/posts/pochti-sem-tysyach-kuzbassovtsev-zaboleli-grippom-i-orvi-za-nedelyu
Последние данные о ситуации с заболеваемостью в регионе сообщили в Роспотребназдоре.
https://avoka.do/posts/pochti-sem-tysyach-kuzbassovtsev-zaboleli-grippom-i-orvi-za-nedelyu
Последние данные о ситуации с заболеваемостью в регионе сообщили в Роспотребназдоре.

Последние данные о ситуации с заболеваемостью в регионе сообщили в Роспотребназдоре.
Ссылка https://avoka.do/posts/pochti-sem-tysyach-kuzbassovtsev-zaboleli-grippom-i-orvi-za-nedelyu
Работа в Кемерово и Кузбассе

Работа в Кемерово: Актуальные вакансии и резюме. Удобный поиск работы в Кемерово. На нашем сайте Вы сможете найти работу в кратчайшие сроки.Работа в Кемерово: Актуальные вакансии и резюме. Удобный поиск работы в Кемерово. На нашем сайте Вы сможете найти работу в кратчайшие сроки.
Ссылка https://rabota.vse42.ru/vacancy/31173932
Почти семь тысяч кузбассовцев заболели гриппом и ОРВИ за неделю
https://avoka.do/posts/pochti-sem-tysyach-kuzbassovtsev-zaboleli-grippom-i-orvi-za-nedelyu
Последние данные о ситуации с заболеваемостью в регионе сообщили в Роспотребназдоре.
https://avoka.do/posts/pochti-sem-tysyach-kuzbassovtsev-zaboleli-grippom-i-orvi-za-nedelyu
Последние данные о ситуации с заболеваемостью в регионе сообщили в Роспотребназдоре.

Последние данные о ситуации с заболеваемостью в регионе сообщили в Роспотребназдоре.
Ссылка https://avoka.do/posts/pochti-sem-tysyach-kuzbassovtsev-zaboleli-grippom-i-orvi-za-nedelyu
"Чудо-женщина: 1984" на обложках грядущего номера Empire
Законопроект об отмене подоходного налога для малоимущих россиян внесен в Госдуму
https://vse42.ru/news/31173980
Депутаты Государственной думы внесли на рассмотрение законопроект относительно налогов на доходы жителей России, которые получают менее двух минимальных размеров оплаты труда (МРОТ) в месяц.
https://vse42.ru/news/31173980
Депутаты Государственной думы внесли на рассмотрение законопроект относительно налогов на доходы жителей России, которые получают менее двух минимальных размеров оплаты труда (МРОТ) в месяц.
Квартирный выгул: как превратить лоджию или балкон в комфортную зону отдыха
https://vse42.ru/articles/31171836
Затянувшаяся эпидемия коронавируса заставила нас придумывать, чем заняться на карантине, мыть руки и соблюдать другие важные правила. Теперь же, когда становится понятно, что вирус не отступит в ближайшее время, мы нашли себе еще одно занятие – обустройство балконов, которые, возможно, в скором времени станут единственным безопасным для "прогулок" местом. Как превратить лоджию в уголок для комфортного отдыха, читайте в нашем материале.
https://vse42.ru/articles/31171836
Затянувшаяся эпидемия коронавируса заставила нас придумывать, чем заняться на карантине, мыть руки и соблюдать другие важные правила. Теперь же, когда становится понятно, что вирус не отступит в ближайшее время, мы нашли себе еще одно занятие – обустройство балконов, которые, возможно, в скором времени станут единственным безопасным для "прогулок" местом. Как превратить лоджию в уголок для комфортного отдыха, читайте в нашем материале.
Свежие новости Кузбасса
- 23:43: Легковой автомобиль сгорел возле дома в Кузбассе
- 23:42: Бившая детей дагестанская учительница лишилась работы
- 23:20: Американка оказалась зажата в спрессованных отходах в мусоровозе
- 23:10: "Ниже и ниже: покосившийся столб возмутил жителей кузбасского города
- 23:05: Петербуржец угрожал женщине пистолетом из-за конфликта на дороге
- 23:00: Девочка сломала позвоночник на школьной горке в Саратове
- 22:47: Общавшаяся с девушками вместо москвича нейросеть нашла ему жену
- 22:29: Собаки съели своего "собрата" в кузбасском поселке
- 22:24: Врачи восстановили мальчику половой орган в Нижневартовске
- 22:10: Неизвестный выбросил трех кошек с 15 этажа в Подмосковье
- 22:07: Приехавшие в Новокузнецк для торговли наркотиками барнаульские студенты лишатся свободы
- 21:47: Таксист занялся мастурбацией при пассажирке и ее ребенке в Санкт-Петербурге
- 21:32: Ученые допустили риск уничтожения человечества ИИ
- 21:18: Листы фанеры зажали сотрудника дверной фабрики в Чувашии
- 21:16: Серийный вор шоколада появился в Новокузнецке




































